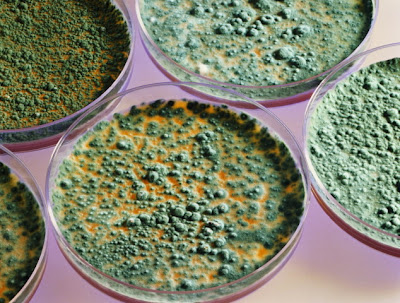

One of many lots of the motive why Black Mold Removal is really important can be because of the health risks. Black Mold is usually thought of probably the most poisonous off Molds. It has been recognized for you to trigger serious well being issues, particularly regarding one’s ability in order to breathe property. In many cases, notably having infants or aged, Black Mold possesses contributed to death. That’s the reason it is extremely essential that will your private home endure a black mannequin removing undertaking whether or not it needs to be done.
Though this health risks related to Black Mold are usually a very powerful motive the key reason why your property should undergo a Black Mold Removal Atlanta undertaking if you have Black Mold in your house, but you can find different causes at the same time. One of those reasons is the value in your home. Mold, notably Black Mold, can considerably lower the worth of your home. One of many causes for which can be the dangers. Householders are advised in opposition to dwelling in homes that have Black Mold. Therefore, if you’re looking to promote your property, it’s greatest to seriously think about using your own home undergo a Black Mold Removal venture first.
In case you are uncertain while to whether or otherwise the actual Mold in your home is Black Mold, you might wish to take into consideration contacting a Mold inspector. These kinds of inspectors their particular data plus quite a lot of helpful tools that will can be utilized to determine whether or not or otherwise the Mold in your house will be again Mold. Additionally, in many circumstances, you’ll discover that a great many Mold inspectors also double as Black Mold Removal pros; therefore, one telephone call will get the Black Mold problem solved very quickly by any means.
Any time knowledgeable Black Mold Removal specialist reveals up to complete the Mold Removal course of, you might need to question them just a few questions. Many instances, we create the Black Mold within our homes, through not focusing on the temperature or moisture in our homes. By talking which includes a Black Mold Removal specialist, you might get indoors information or tips about how you can prevent a Black Mold recurrence from happening. Almost all Mold Removal specialist can be very happy to coach oneself Black Mold, how to prevent the item coming from returning once more, as properly as dangers of it.
Don’t be low-cost on the subject of the cost of Mold Removal. Black Mold Removal out of your partitions involves numerous specialized work. To become assured your Black Mold downside won’t recur, rent a good professional to help carry out the job efficiently and punctiliously. You’ll want to make sure how the business a person select will be reliable.
Research these people within the native Better Business listings as well as find 1 using great references along with a trusting customer base. The continued well being for your family is certainly worth the extra cost.
You will generally want so as to add the cost of external lodgings for you to the value of eradicating your Mold problem. Till your Mold drawback is completely eradicated, you’ll doubtless have to relocate your total family. You may go back to your private home confidently once the Black Mold continues to be completely removed. Until your Mold drawback is completely solved, you may hire another condo or house, stay inside a hotel, or perhaps stay with family as well as friends. Black Mold tends to take extra time for you to completely clean.
That extra time is also an extra price, which some individuals are unprepared for. Because being dedicated to friends or even family shouldn’t be all the time a good option, placed apart extra cash because of this hotel as well as alternate home. The cost because of this rental is perhaps coated via your owners insurance.
Before a person visit any decisions, read your current coverage completely. An individual may want to supply evidence your situation on your insurance coverage company earlier than they’ll compensate an individual for your various accommodations.
Humidity is the vital thing ingredient regarding Mold Growth. Several widespread options for damp are Flooding, dripping faucet, roof leak, cracks inside your ceiling or simply basis, inaccurately installed exhaust enthusiast within items much like the kitchen’s, utility room or perhaps bogs, damp crawl areas or perhaps basements, gutter which can be shockingly put in rain gutters, windows which are not covered correctly as well as your masonry. Elimination is actually the simplest way to forestall Mold Growth. This calls for a visible demarche in your home to look for any sort of original leaking, projecteur on your ceilings or perhaps partitions.
Whenever the factor is anything that pr?texte concern that’s where you want to complete a complete tourn?e plus consider using an analysis by method of a certified Mold tester as well as hygienists. They have working out, equipment plus experience to evaluate, check, making the essential suggestions had to maintain your self safe. A professional will take some air types of both the outdoor and indoor air to determine in case you have Mold present in your house. The test with the in-depth bodily examination will determine typically the plan of action which is necessary to take away the Toxic Mold from your personal home.
Experience of Mold could make you goes through some sort of hypersensitive answer by respiratory your Mold Spores. These types of symptoms might include viven high temperature or maybe asthma, wheezing, nose together with cavit? traffic jams, pores and skin irritation, intertrigos, cough, prurit in the warm, nostril and bronchi. The signs and symptoms consist of people depending on their present well being reputation. We know youngsters, older people the ones people with made up defense signs routinely have more severe difficulties. When the Toxic Mold isn’t removed this specific can end result in serious health issues not forgetting typically the costly home problems.
Black Mold on concrete can take many forms. Concrete is a porous substance, and your basement ground will get a variety of moisture from the bottom beneath it.

.jpg)

No comments:
Post a Comment